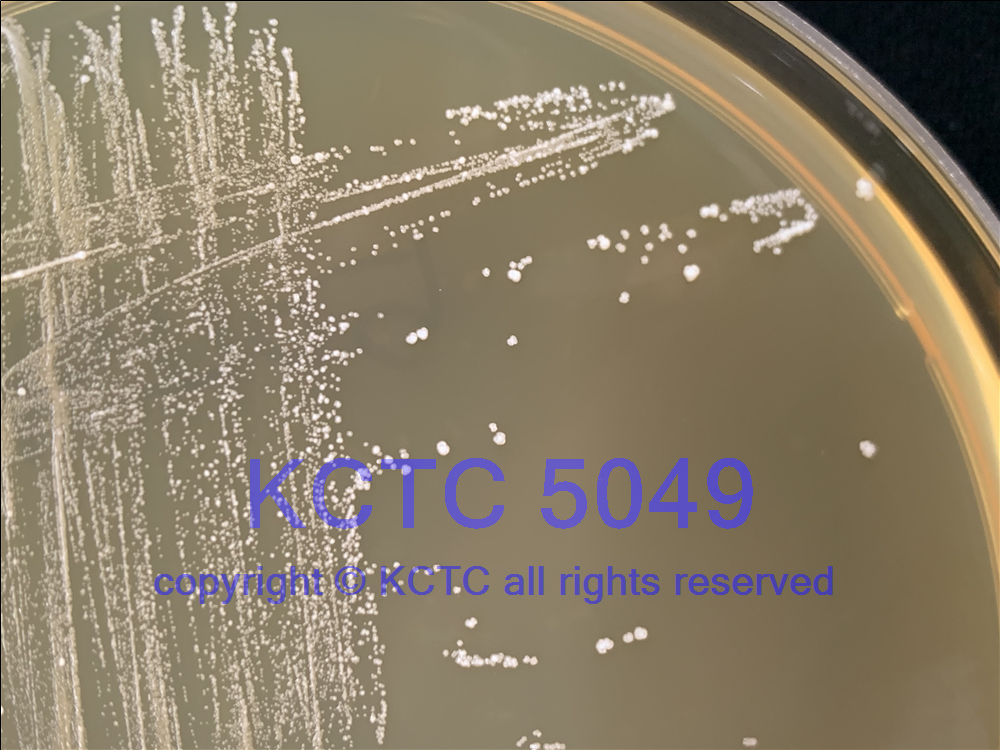

中文名稱:發(fā)酵乳桿菌
拉丁名稱:Lactobacillus fermentum
來源歷史:--JCM
原始編號(hào):19 LC 3
原產(chǎn)國(guó):美國(guó)
模式菌株:是
生物安全級(jí)別:一級(jí)
其它保藏中心編號(hào):JCM 1137=ATCC 11739=DSM 20055=JCM 12530=LMG 9846
KCTC 5049 19 LC 3, ATCC [11739], BCRC [12194], CECT [562], CIP [102981], DSM [20055], JCM [1137], KCTC [3547], LMG [9846], NCFB [928], NRRL [B-1840]
培養(yǎng)基編號(hào):58
培養(yǎng)溫度:37℃
培養(yǎng)時(shí)間:24-48h
需氧類型:兼性厭氧
分離基物:唾液
采集地:**
保存方法:冷凍干燥管保藏